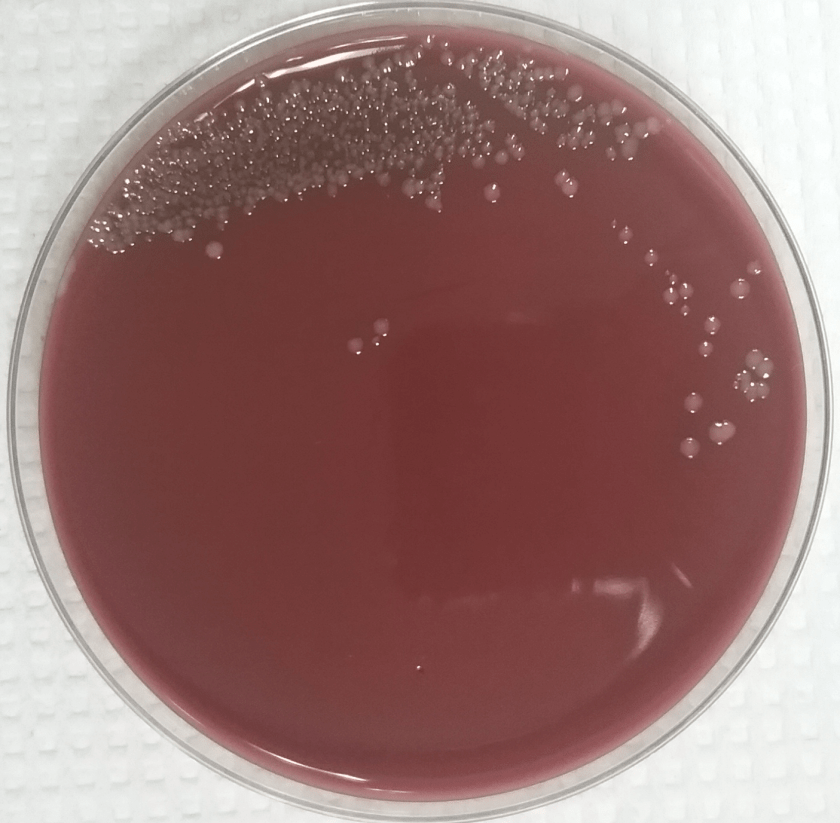
pastmult2.png

Case History
The patient is a 64 year old man with a past medical history significant for coronary artery disease, chronic systolic heart failure, poorly controlled type 2 diabetes mellitus, atrial fibrillation, chronic respiratory failure on home oxygen, squamous cell carcinoma of the larynx status post chemotherapy, and radiation and lung adenocarcinoma status post microwave ablation. On the morning of presentation, the patient’s wife was unable to wake him and found him to have low oxygen saturation with a home monitor. Three days prior to presentation, the patient had been evaluated in the emergency department for leg and back pain for which he was prescribed hydromorphone. He had also been experiencing nausea for several days, with fever (101° F) and chills. His wife endorses several sick contacts at home. He has been admitted to the hospital numerous times within the past year for respiratory failure, most recently 6 months ago. The patient also was given a course of antibiotics one month prior for a “cold.”
Enroute to the emergency department, EMS administered naloxone without significant response. Upon arrival to the hospital, his vital signs were: temperature 97.9° F, heart rate 69, respiratory rate 23, blood pressure 104/57, 95% SpO2. He was found to have a white blood cell count of 15,690/cm2 and a chest x-ray showed diffuse patchy airspace opacities concerning for multifocal pneumonia. A viral swab was collected and blood cultures were drawn. He was started on levofloxacin for suspected community acquired pneumonia.
His blood cultures were found to be growing gram negative coccobacilli.

Figure 1. Gram stain from a positive blood culture illustrating small Gram negative coccobacilli (100x, oil immersion).
Figure 2. Chocolate agar illustrating the convex, smooth and gray colonies.
MALDI-TOF identified the organism as Pasteurella multocida. Further investigation revealed that the patient recently acquired a puppy (4-month-old) that bit him while playing. Antibiotics were switched to IV ceftriaxone and the patient recovered. He was later discharged on IV antibiotics and home healthcare.
Discussion
Pasteurella multocida is a non-motile gram negative coccobacillus that is oxidase-positive and glucose fermenting. Most isolates don’t on MacConkey agar. It is a known cause of disease amongst humans and animals, but is commonly a commensal organism found in domesticated and wild animals. It is most notably found in the oropharynx of cats, dogs, pigs, and birds. The majority of P. multocida infections are due to animal exposure, either from traumatic inoculation or proximity. Soft tissue infections are most common, resulting from animal bite or scratch. It has also been known to cause pulmonary disease in the form of multifocal pneumonia in those with pre-existing chronic lung disease. It is also a rare cause of septic arthritis, osteomyelitis, endocarditis and meningitis in those with disseminated disease.
P. multocida virulence factors include an endotoxin and an antiphagocytic capsule. It grows well on routine laboratory media but not on MacConkey. Colonies appear convex, smooth, gray and nonhemolytic. Mucoid variants can also occur. It has been described as having a musty or mushroom odor, although sniffing plates is not recommended. Susceptibility testing is usually not required as it is universally susceptible to β-lactams. However, CLSI does provide breakpoints for suggested drugs should the need for testing arise.
References
Tille, P. M., & Forbes, B. A. (2014). Bailey & Scott’s Diagnostic Microbiology (Thirteenth edition.). St. Louis, Missouri: Elsevier.
Kuhnert P; Christensen H, eds. (2008). Pasteurellaceae: Biology, Genomics and Molecular Aspects. Caister Academic Press.
-Clayton LaValley, MD is a 1st year anatomic and clinical pathology resident at the University of Vermont Medical Center.

-Christi Wojewoda, MD, is the Director of Clinical Microbiology at the University of Vermont Medical Center and an Assistant Professor at the University of Vermont.
V.helpful… Keep it up